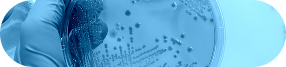

Welcome to Triangle Molecular Toxicology, a CLIA-certified toxicology laboratory committed to delivering accurate, comprehensive, and fast drug testing services to you and our partners nationwide.
Based in Durham, North Carolina, Triangle Molecular Toxicology specializes in providing a wide range of testing options that offer flexibility and convenience.
We use cutting-edge technology to deliver the highest quality services to a broad range of clients. From pain management clinics to substance abuse counseling programs, Triangle Molecular Toxicology is dedicated to serving everyone with detailed and easy-to-read testing reports.

Urine testing is the most widely used method for drug screening due to its convenience, affordability, and fast turnaround time of 48–72 hours. Our lab tests for a broad range of substances, including alcohol, opioids, amphetamines, THC, fentanyl, benzodiazepines, methamphetamines, and more. This service is ideal for treatment centers seeking accurate results delivered quickly and efficiently.
Blood testing provides a precise snapshot of current substance use and is especially useful in cases requiring immediate detection. Our laboratory is equipped to test for common substances such as alcohol, opioids, THC, fentanyl, methamphetamines, benzodiazepines, and oxycodone. This method is ideal for situations that demand high accuracy and up-to-the-minute results.
This minimally invasive method involves collecting small blood samples on filter paper, making it ideal for outpatient and remote settings. Blood spot testing allows for the detection of substances including alcohol, nicotine (cotinine), fentanyl, amphetamines, THC, and opioids with reliable precision and minimal discomfort for the donor.
Plasma testing offers high sensitivity and detailed analysis by examining the fluid portion of blood. It is commonly used to monitor specific substance levels and to confirm prior test results. Substances detected include THC, opioids, benzodiazepines, fentanyl, methamphetamines, buprenorphine, and tricyclic antidepressants.
To ensure the integrity of all collected samples, our lab conducts extensive adulteration testing. We detect tampering and dilution through creatinine levels, pH measurements, specific gravity tests, and oxidant screening. These checks are essential in settings where attempts to falsify results are more likely, such as addiction treatment centers and detox programs.
Our advanced toxicology panels cover over 60 individual analytes, making our services highly adaptable to the needs of medical professionals and institutions. We test for a wide range of substances including alcohol, fentanyl, THC, buprenorphine, amphetamines, methamphetamines, benzodiazepines, oxycodone, tramadol, and more. This broad-spectrum testing helps providers make informed decisions with confidence.